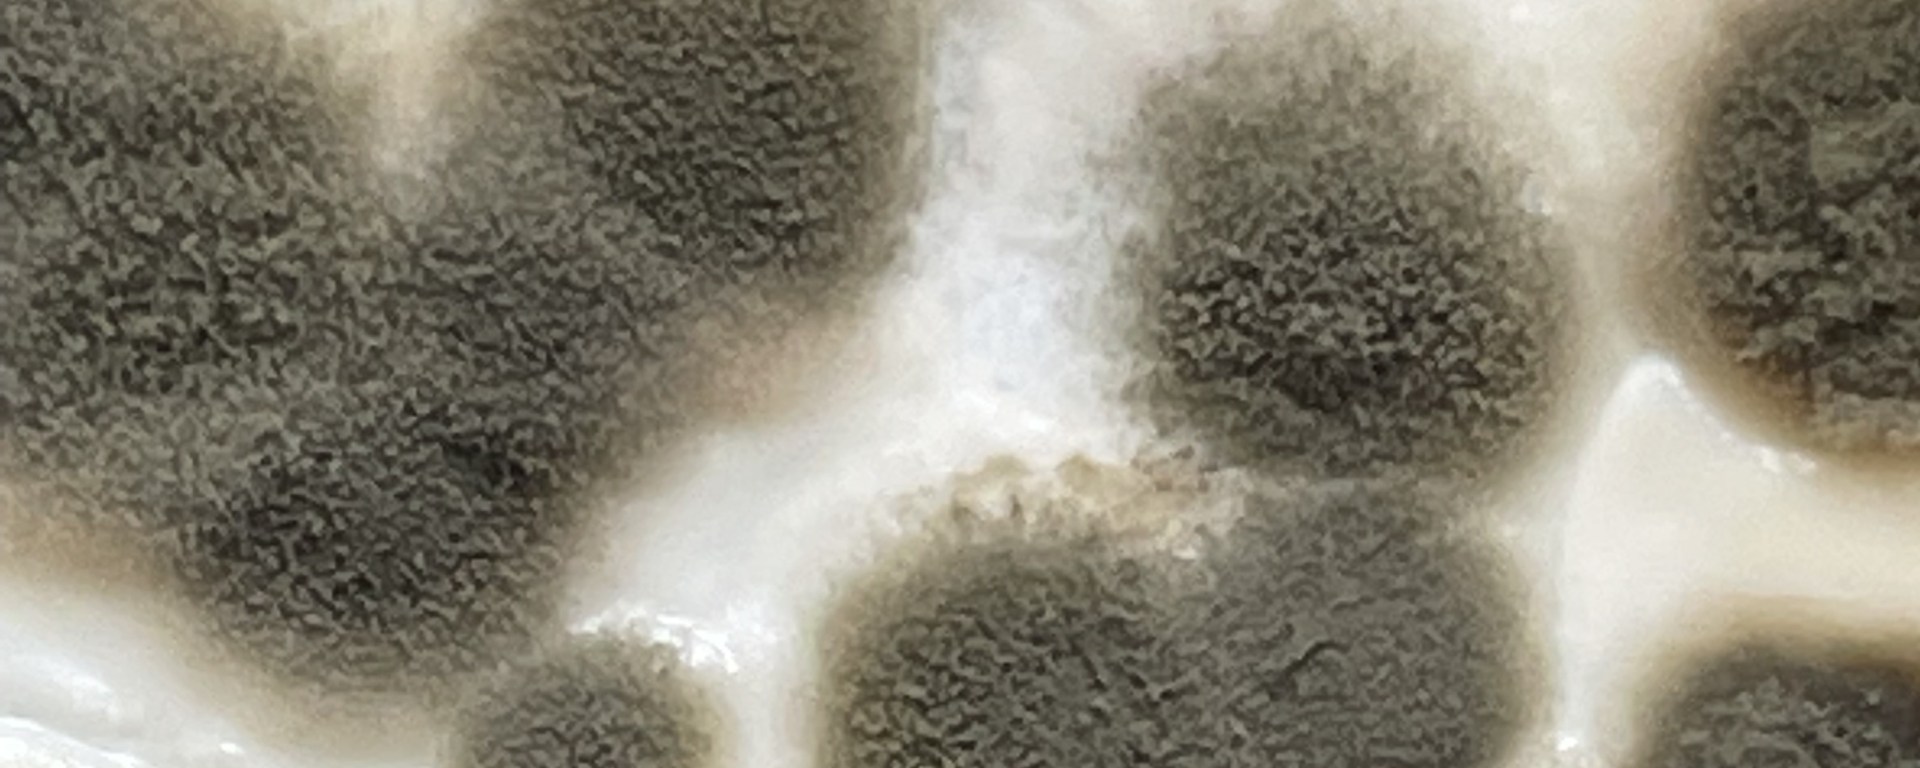
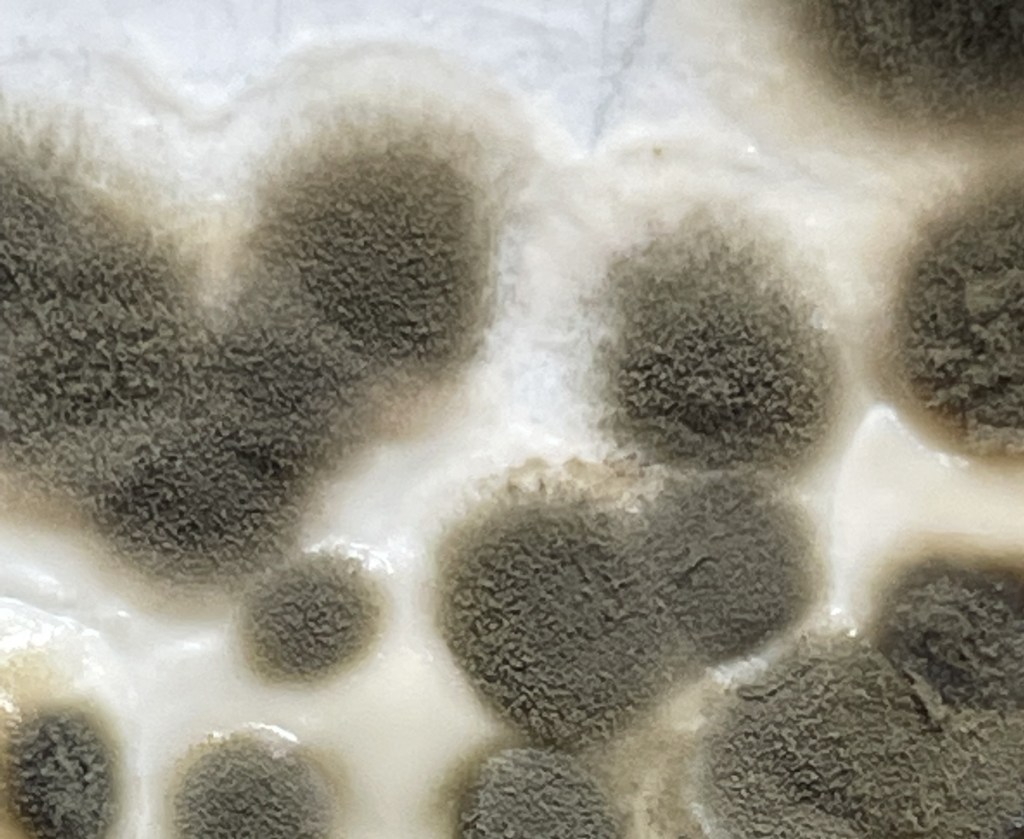

Unsichtbar für unsere Augen sind wir von Sporen umgeben, die nur darauf warten, auf den richtigen Grund zu fallen. Nährstoffe, Feuchtigkeit und Wärme lassen wie durch Zauberhand winzige Wälder wachsen, sich vermehrend, neue Sporen abstoßend und sich so immer weiter ausdehnend. Auch göttliche Liebe verbreitet sich auf diese verborgene Art in unserer Welt. Bin ich bereit, ihr Nährboden zu sein?